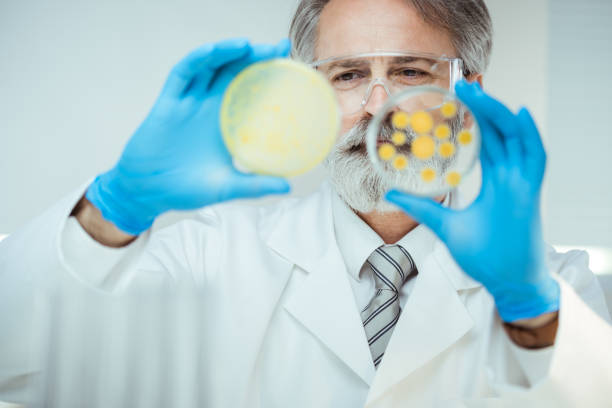
Program Director/Professor
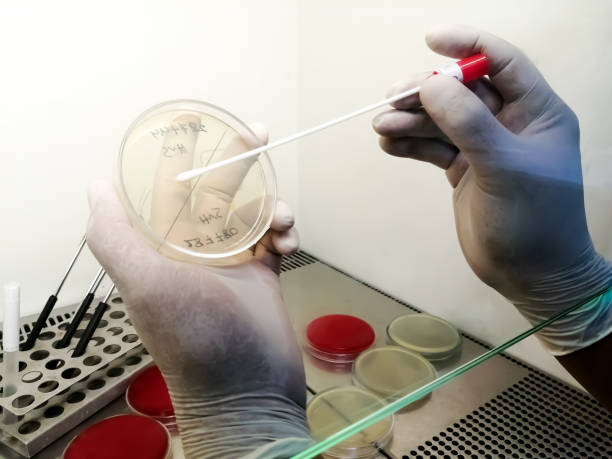
Clinical Bacteriologist (Specialized Role)
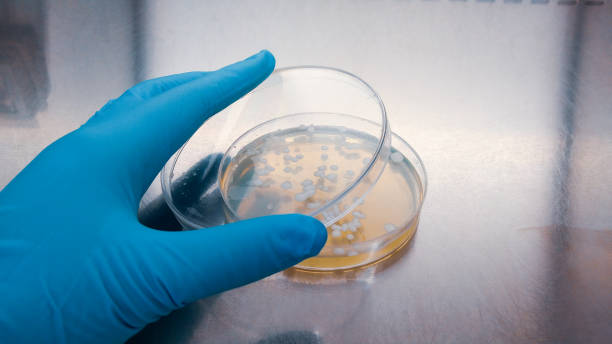
Industrial Bacteriologist (Specialized Role)

Leading Professions
Explore various career paths and opportunities in Bacteriologist
Explore various career paths and opportunities in Bacteriologist

Early-career bacteriologists establish research or applied roles, often joining academic groups, government bodies, or industries while developing their expertise and project portfolio. They build independent research by managing studies on bacterial applications and performing routine analyses. Their work establishes professional reputation through successful project outcomes and collaboration with peers. They are developing specialty expertise, often focusing on specific areas like clinical bacteriology or environmental microbiology to build a niche within the field.

Mid-career specialists maintain active research portfolios, often developing subspecialty interests within bacteriology such as bacterial genomics or industrial microbiology. They manage complex projects, including large-scale bacterial studies or drug development, often serving as referral experts for challenging research questions. Their expertise attracts funding and partnerships, solidifying their role in scientific networks. They are central to research delivery, balancing project duties with mentorship of junior colleagues and participation in advisory committees.

Experienced bacteriologists often take leadership roles, overseeing research teams or programs while mentoring junior researchers and shaping scientific protocols. They provide research leadership by guiding study standards and integrating new technologies into practice. Their experience guides program direction, influencing policy, resource allocation, and training initiatives. They are crucial for organizational excellence, ensuring high-quality research output and fostering a culture of continuous improvement within their teams.
Top-level bacteriologists may direct research programs or academic departments, combining scientific expertise with administrative leadership and teaching responsibilities. They provide institutional leadership by overseeing bacteriological research initiatives and educational curricula at universities or institutes. Their influence shapes the specialty through policy advocacy, published works, and training the next generation of bacteriologists. They are essential for advancing the field, driving innovation in bacterial applications and sustainable methodologies.
Specialists focus exclusively on bacteria in medical contexts, developing expertise in diagnosing and treating bacterial infections. They focus on patient care, addressing unique challenges of antimicrobial resistance and infection control. Their specialization addresses health factors, tailoring solutions to minimize disease impact. They are essential for healthcare management, often working in dedicated hospitals or diagnostic centers to provide impactful, science-driven solutions.
Experts in this track work in biotechnology or industrial sectors, focusing on commercial applications of bacteria, such as in food production or waste treatment. They drive innovation by optimizing bacterial processes for scalability and efficacy in industrial settings. Their work bridges science and industry, ensuring product development aligns with market needs and regulatory standards. They are key to industrial advancement, pushing the boundaries of bacteria as a resource in high-demand sectors.